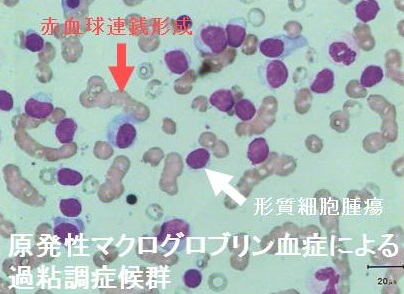
原発性マクログロブリン血症 原発性マクログロブリン血症

多発性骨髄腫と甲状腺・高カルシウム血症,単クローン性ガンマグロブリン血症[橋本病 バセドウ病 甲状腺エコー 長崎甲状腺クリニック 大阪]
甲状腺:専門の検査/治療/知見② 橋本病 バセドウ病 甲状腺エコー 長崎甲状腺クリニック大阪
甲状腺専門の長崎甲状腺クリニック(大阪府大阪市東住吉区)院長が海外(Pub Med)・国内論文に眼を通して得た知見、院長自身が大阪市立大学(現、大阪公立大学) 代謝内分泌内科で得た知識・経験・行った研究、日本甲状腺学会 年次学術集会で入手した知見です。
長崎甲状腺クリニック(大阪)以外の写真・図表はPubMed等において学術目的で使用可能なもの(Creative Commons License)、public health目的で官公庁・非営利団体等が公表したものを一部改変しています。引用元に感謝いたします。尚、本ページは長崎甲状腺クリニック(大阪)の経費で非営利的に運営されており、広告収入は一切得ておりません。
甲状腺・動脈硬化・内分泌代謝・糖尿病に御用の方は 甲状腺編 動脈硬化編 甲状腺以外のホルモンの病気(副甲状腺/副腎/下垂体/妊娠・不妊など) 糖尿病編 をクリックください
長崎甲状腺クリニック(大阪)は甲状腺専門クリニックです。多発性骨髄腫・原発性マクログロブリン血症の診療を行っておりません。
Summary
多発性骨髄腫は骨髄内の癌化した形質細胞が骨を破壊しながら増殖。骨髄腫細胞が産生する①IL-6(インターロイキン6)が破骨細胞を活性化、骨融解による骨痛、骨折、局所性骨溶解性高カルシウム(Ca)血症(LOH)(甲状腺機能亢進症/バセドウ病の骨融解による骨痛、甲状腺癌の骨転移痛、原発性副甲状腺機能亢進症の線維性骨炎と鑑別)②免疫抗体の断片(M蛋白)が過粘稠度症候群、甲状腺機能低下症の原因となる甲状腺アミロイドーシス、骨髄腫腎をおこす④汎血球減少。治療薬サリドマイドとレブラミド®(レナリドミド)、ポマリドミド(ポマリスト®)が薬剤性甲状腺機能低下症の副作用。
Keywords
多発性骨髄腫,形質細胞,インターロイキン6,局所性骨溶解性高カルシウム血症,甲状腺,M蛋白,過粘稠度症候群,甲状腺機能低下症,アミロイドーシス,ボルテゾミブ,レナリドミド
高齢化に伴い多発性骨髄腫患者は増加しています。
多発性骨髄腫とは
多発性骨髄腫では、骨中の骨髄(赤血球、白血球、血小板を作る場所)にて、がん化した形質細胞(Bリンパ球が分化した細胞)[腫瘍性形質細胞]が周囲の骨を破壊しながら増殖します。
多発性骨髄腫の病態
- 骨髄腫細胞で産生されるIL-6 [インターロイキン6(Interleukin-6)]が、破骨細胞を活性化させて骨破壊が生じます。腰背・肋骨などの骨痛は安静時に軽く、体動時は強く、場所も移動します。NSAID 無効の腰痛にて、体動と自力歩行が困難になるケースも(オピオイド投与)。痛み無く、骨折で発見される事もあります。(甲状腺機能亢進症/バセドウ病の骨融解による骨痛、甲状腺癌の骨転移痛、原発性副甲状腺機能亢進症の線維性骨炎と鑑別。)
- 骨が溶け出し、血液中のカルシウム濃度が上昇(高カルシウム血症)→意識障害・腎障害に至ります(大量生理食塩水輸液+ビスホスホネート製剤投与)[局所性骨溶解性高カルシウム(Ca)血症(local osteolytic hypercalcemia: LOH)]。
甲状腺機能亢進症/バセドウ病の骨融解、悪性リンパ腫[腫瘍随伴体液性高カルシウム(Ca)血症(humoral hypercalcemia of malignancy: HHM)]、原発性副甲状腺機能亢進症による高カルシウム血症と鑑別。
- 正常な血球が作られず、貧血、免疫不全、出血傾向がおこります。血清正常免疫グロブリン(IgG、IgA、IgM)全てが明らかに減少(IgG型は異常なIgG上昇)。巨赤芽球性貧血(ビタミンB12,葉酸欠乏)を伴うことが多い。
- 骨髄腫細胞は単クローン性免疫グロブリンあるいはその構成成分(重鎖、軽鎖)を多量に作ります(M蛋白)。血清総蛋白(TP)が増加、血液は粘性上昇して循環が悪くなり、頭痛や視力障害を来します(過粘稠度症候群)。深部静脈血栓症・肺塞栓症・脳梗塞がおこり易い。
M蛋白がアミロイドという不溶性物質に変性し、甲状腺・消化管や腎臓、心臓、神経等の組織に沈着。甲状腺機能低下症・腎障害(ネフローゼ)・心不全・神経障害・手根管症候群に至ります(アミロイドーシス)。
免疫グロブリンの軽鎖(L鎖)であるBence Jones蛋白(BJP)は分子量が小さいため尿中に漏出し、血清総蛋白(TP)は減少。
ただし、非分泌型でM蛋白は認められず、血清総蛋白(TP)も増加しません。正常γ-グロブリンは抑制されます。
- 骨髄腫腎:免疫抗体の断片である軽鎖による尿細管障害と糸球体障害(糸球体に沈着)。多発性骨髄腫で特に脱水がある場合、腎不全をおこす危険があるため、造影CT/MRIは 「原則禁忌(造影剤添付文書)」。
多発性骨髄腫の検査所見・診断
- 血清総蛋白増加、アルブミン低下
- 血清蛋白免疫電気泳動;免疫グロブリンの種類を同定
- 骨髄穿刺;異型形質細胞の増殖を認めます。
多発性骨髄腫の治療
多発性骨髄腫の治療開始基準は骨髄で形質細胞が10%以上かつSLiM-CRABを合併した患者です。
※CRAB; 高カルシウム血症 / 腎不全 / 貧血 /骨病変の臓器障害
SLiM : 骨髄中形質細胞≧60%、 非腫瘍由来の血清遊離軽鎖比≧100、 MRIで2カ所以上の5mmを超える巣状病変
多発性骨髄腫の導入療法は新規薬剤を2剤以上使用することが推奨されています。
- 免疫調節薬;サリドマイドと、その誘導体レブラミド®(レナリドミド)、ポマリドミド(ポマリスト®)(甲状腺関連の副作用)
- ステロイド剤;デキサメタゾン等。プレドニゾロン換算20mg以上で1カ月以上投与する時は、ニューモシスチス肺炎予防のためST合剤(バクタ®)、アトバコン(サムチレール®)内服、ペンタミジン(ベナンバックス®)吸入が必要。
元々、多発性骨髄腫は過粘稠度症候群(深部静脈血栓症・肺塞栓症・脳梗塞)を起こし易く、デキサメタゾンとの併用で危険性が高まるため、少量アスピリン予防投与が必要。
- プロテアソーム阻害剤;ベルケイド注®(ボルテゾミブ)はプロテアソームを選択的に阻害する分子標的薬です。副作用で帯状疱疹をおこす可能性があるため、アシクロビルの予防投与が必要。
- エロツズマブ、ダラツムマブなどのモノクローナル抗体
- ビスホスホネート製剤;特にゾレンドロネート(ゾメタ®)は病的骨折・骨痛・高カルシウム血症に対する効果がある。(Cochrane Database Syst Rev. 2017 Dec 18;12(12):CD003188.)
- chimeric antigen receptor(CAR)-T細胞療法(キメラ抗原受容体T細胞療法);B-cell Maturation Antigen(BCMA)を標的とした治療法。3クラス(プロテアソーム阻害薬,免疫調節薬,抗CD38モノクローナル抗体)不応の再発難治性骨髄腫患者に。すぐに再発し無増悪生存期間は比較的短いため、あまり役には立たない。[Lancet. 2021 Jul 24;398(10297):314-324.]
- エルレフィオ®(エルラナタマブ:Elranatamab)二重特異性抗体(BCMAとCD3に結合)
免疫調節薬サリドマイドと、その誘導体レブラミド®(レナリドミド)は血管新生抑制・抗TNF作用を有し、多発性骨髄腫・骨髄異形成症候群(MDS)に有効です。
レブラミド®(レナリドミド)は副作用として5-10%に甲状腺機能低下症をおこします(Am J Hematol. 2011 Jun; 86(6):467-70.)。その機序は解明されていませんが、
- 薬剤が甲状腺に直接的な毒性を及ぼす(Ann Hematol. 2008 May; 87(5):345-52.)
- 濾胞細胞へのヨード(ヨウ素)取り込みを抑制(Br Med J. 1958 Jan 11; 1(5062):84-5.)
- 甲状腺の血管新生阻害(Ann Hematol. 2008 May; 87(5):345-52.)
- サイトカイン(細胞化学物質)を介し甲状腺の自己免疫を誘発(Am J Med. 2002 Apr 1; 112(5):412-3.)
などの可能性が考えられます。散発的に破壊性甲状腺中毒症が惹起されることもあります。
元々、多発性骨髄腫は過粘稠度症候群(深部静脈血栓症・肺塞栓症・脳梗塞)を起こし易く、レブラミド®(レナリドミド)投与でその危険性は高まるため、少量アスピリン予防投与が必要。
ポマリドミド(ポマリスト®)もサリドマイド誘導体で、ボルテゾミブ・レナリドミド治療抵抗性または治療後に再発した多発性骨髄腫の治療に用いられます。甲状腺機能低下症の副作用があります (Endocrinol Diabetes Metab Case Rep. 2017 Dec 15;2017:17-0110.)
多発性骨髄腫の予後
多発性骨髄腫は難治性が高く、治療による奏効が得られても、再発を繰り返します。
多発性骨髄腫の予後を左右する因子は
- 血清LD(LDH)
- 血清ベータ2マイクログロブリン(β2-MG)
です。
多発性骨髄腫治療薬の進歩により、全生存期間(OS)は7-10年に改善しています(Hematology Am Soc Hematol Educ Program. 2014 Dec 5;2014(1):255-61.)。
形質細胞性白血病は、多発性骨髄腫の1亜型
- 原発性;発症時より白血病の病像
- 2次性多発性骨髄腫の経過中に白血化
に分けられる。治療は、VAD療法が主体。予後は7~8ヵ月と極めて不良。
意義不明の単クローン性ガンマグロブリン血症(MGUS)]は癌化していない形質細胞がモノクローナル抗体を産生する病気。免疫抗体の断片(M蛋白)による軽度のM蛋白血症を認め、末梢臓器障害は無いことになっているが、末梢神経障害やアミロイド甲状腺腫(甲状腺アミロイドーシス)を起こした報告あり。1年に約1%の頻度で、多発性骨髄腫やアミロイドーシス、原発性マクログロブリン血症、悪性リンパ腫に進行。M蛋白血症を橋本病の0.7%、甲状腺悪性リンパ腫23.1%に認めた。
意義不明の単クローン性ガンマグロブリン血症,MGUS,癌化していない形質細胞,モノクローナル抗体,甲状腺腫,甲状腺,橋本病,悪性リンパ腫
意義不明の単クローン性ガンマグロブリン血症(MGUS)
意義不明の単クローン性ガンマグロブリン血症[MGUS(Monoclonal gammopathy of undetermined significance)]は、がん化していない形質細胞が単クローン性ガンマグロブリン(モノクローナル抗体)を産生する病気です。70歳以上の高齢者の5%以上で認められます。
免疫抗体の断片(M蛋白)による軽度のM蛋白血症(血清濃度 3.0 g/dL 未満)を認めますが、
- 骨髄中単クローン性形質細胞が10%未満
- 通常無症候性で、クローン性形質細胞疾患による末梢臓器障害(骨・腎・貧血・免疫不全・出血傾向・過粘稠度症候群・アミロイドーシス)が無い
のが特徴です。しかし、末梢神経障害を伴うこともあり、骨量減少や骨折が起こり易くなります。
意義不明の単クローン性ガンマグロブリン血症(MGUS)は、1年に約1%の頻度で、多発性骨髄腫やアミロイドーシス、原発性マクログロブリン血症(Waldenström マクログロブリン血症)、悪性リンパ腫に進行します。(N Engl J Med. 2002 Feb 21;346(8):564-9.)
意義不明の単クローン性ガンマグロブリン血症(MGUS)からアミロイド甲状腺腫(甲状腺アミロイドーシス)
意義不明の単クローン性ガンマグロブリン血症(MGUS)からアミロイド甲状腺腫(甲状腺アミロイドーシス)を起こした報告があります。ラムダ型の軽鎖アミロイドでした。(AACE Clin Case Rep. 2019 Jun 26;5(5):e326-e329.)
橋本病とM蛋白血症
橋本病患者 681名に、血清蛋白電気泳動を実施。1名に前甲状腺悪性リンパ腫と13名に甲状腺悪性リンパ腫が判明し、残りの667例名は橋本病のみ。M蛋白血症を認めたのは、橋本病のみ5例(0.7%)、前甲状腺悪性リンパ腫1例と、甲状腺悪性リンパ腫3例(23.1%)。甲状腺内M蛋白が、後2者に認められ、甲状腺由来であると考えられます。 [Matsubayashi, S.: "Monoclonal gammopathy in Hashimoto's thyroidits and malignant lymphoma of the thyroid" Journal of Clinical Endocrinology and Metabolism. 63. 1136-1139 (1986)]
単クローン性ガンマグロブリン血症を伴うMALT甲状腺リンパ腫
MALT甲状腺悪性リンパ腫で本態性M蛋白血症[単クローン性ガンマグロブリン(M蛋白)血症]を伴うことがあります(Aust N Z J Med. 1992 Oct;22(5):510.)。
クロウ・フカセ症候群[Clow-Fukase症候群:クロウ・深瀬症候群:POEMS症候群]では、形質細胞の異常増殖により産生される血管内皮増殖因子(VEGF)の血管透過性亢進・血管新生作用で、末梢神経障害・臓器腫大・内分泌異常[顕在性甲状腺機能低下症・潜在性甲状腺機能低下症・副腎不全・高プロラクチン血症・女性化乳房・性腺機能低下症]が起きる。甲状腺機能は治療内容に関係なく有意に改善。治療前に甲状腺機能低下症だった患者は、無増悪生存期間(PFS)および全生存期間(OS)が短くなる。
クロウ・フカセ症候群,Clow-Fukase症候群,クロウ・深瀬症候群,POEMS症候群,血管内皮増殖子,VEGF,甲状腺,臓器腫大,内分泌異常,甲状腺機能低下症
クロウ・フカセ症候群[Clow-Fukase症候群:クロウ・深瀬症候群:POEMS症候群]では、形質細胞の異常増殖により産生される血管内皮増殖因子(VEGF)が、
- 末梢神経障害(手足先のしびれ/脱力)[polyneuropathy(P)]
- 臓器腫大;肝脾腫[organomegaly(O)]
- 内分泌異常(女性化乳房、甲状腺機能低下症)[endocrinopathy(E)]
- 多発する骨硬化性病変や硬化縁を伴う溶骨性病変、M蛋白(多発性骨髄腫と同じ)[M-protein(M)]
- 皮膚症状(色素沈着、剛毛、血管腫)[skin change(S)]
などの症状を引きおこします。症状は非特異的なので、しばしば診断が遅れます。
VEGFは強力な血管透過性亢進・血管新生作用で、手足のむくみ/胸水/腹水の貯留もおこします。キャッスルマン病に合併することもあります。
クロウ・フカセ症候群(POEMS症候群)の治療は、レナリドミド(5-10%に甲状腺機能低下症を発症)+デキサメサゾン療法(Rd療法)、末梢造血幹細胞移植(ASCT)。
同じく血管内皮増殖因子(VEGF)が過剰産生される病気に、RS3PE症候群があります。こちらは形質細胞でなく、悪性リンパ腫などの悪性腫瘍、シェーグレン症候群において産生されます。
血清VEGF測定(保険適応外)
クロウ・フカセ症候群[Clow-Fukase(深瀬)症候群:POEMS症候群]の甲状腺異常
甲状腺機能低下症はクロウ・フカセ症候群[Clow-Fukase(深瀬)症候群:POEMS症候群]の約70%に認められる最も一般的な内分泌障害で、浮腫・滲出液を増悪させます(Leuk Lymphoma. 2009 Dec;50(12):2013-6.)。
- 顕在性甲状腺機能低下症(約65%)
- 潜在性甲状腺機能低下症(約35%)
クロウ・フカセ症候群[Clow-Fukase(深瀬)症候群:POEMS症候群]に対して、レナリドミド(5-10%に甲状腺機能低下症を発症)+デキサメサゾン療法(Rd療法)を行うと、甲状腺機能低下症が改善します(Leuk Lymphoma. 2019 Feb;60(2):483-487.)
Yangらの報告では、
甲状腺機能は治療内容に関係なく有意に改善。治療前に甲状腺機能低下症だった患者は、無増悪生存期間(PFS)および全生存期間(OS)が短くなる(3年PFS率・OS率は68.9%・82.8%、非甲状腺機能低下症患者では82.5%・92.8%)。
原発性マクログロブリン血症(Waldenström マクログロブリン血症)はIgMを産生する低悪性度B細胞リンパ腫)。MタンパクはIgM由来で、IgMとIgGが甲状腺ホルモンに結合しホルモン作用を阻害するため、甲状腺機能低下症を来す。13.3%が甲状腺疾患(潜在性甲状腺機能低下症・顕在性甲状腺機能低下症)を合併し、無増悪生存期間・全生存期間の短縮、有害治療反応と有意に関連。原発性マクログロブリン血症(Waldenström マクログロブリン血症)治療後2次発癌は、急性骨髄性白血病、びまん性B細胞リンパ腫、甲状腺癌などが多い。
原発性マクログロブリン血症,Waldenströmマクログロブリン血症,IgM,低悪性度B細胞リンパ腫,Mタンパク,甲状腺ホルモン,甲状腺機能低下症,甲状腺,治療後2次発癌,甲状腺癌
原発性マクログロブリン血症(Waldenström マクログロブリン血症)におけるIgMとIgGは、甲状腺ホルモンに結合しホルモン作用を阻害するため、甲状腺機能低下症を来す可能性があります。[J Clin Endocrinol Metab. 1982 May;54(5):1045-50.]
原発性マクログロブリン血症(Waldenström マクログロブリン血症)患者の13.3%が甲状腺疾患(潜在性甲状腺機能低下症・顕在性甲状腺機能低下症)を合併し、無増悪生存期間(PFS)・全生存期間(OS)の短縮、有害治療反応と有意に関連します。
合併する甲状腺疾患は血清IgM値の低下と有意に関連しており、甲状腺ホルモンとIgMの異常な結合に起因すると推測されます。
甲状腺疾患の合併(特に潜在性甲状腺機能低下症)は、無進行生存期間(PFS)の独立した予後因子となります。
[Front Oncol. 2022 May 13;12:870258.]
原発性マクログロブリン血症(Waldenström マクログロブリン血症)では、過粘稠症候群、網膜静脈の怒張・ねじれた網膜静脈(ソーセージ様、ソーセージリンク様)、アミロイドーシス(甲状腺アミロイドーシスも)を引きおこします。[Radiology. 2017 Aug;284(2):597-602. ]
原発性マクログロブリン血症(Waldenström マクログロブリン血症)患者の24.3%が悪性腫瘍を合併し、そのうち63%は原発性マクログロブリン血症(Waldenström マクログロブリン血症)診断前から存在していた。[Clin Lymphoma Myeloma Leuk. 2011 Feb;11(1):88-92.]
原発性マクログロブリン血症(Waldenström マクログロブリン血症)の治療後2次発癌は、急性骨髄性白血病(AML)、びまん性B細胞リンパ腫(DLBCL)、甲状腺癌、悪性黒色腫(メラノーマ)、肺癌、尿路癌が多い。[Leuk Lymphoma. 2017 Apr;58(4):773-780.][Cancer. 2015 Jul 1;121(13):2230-6. ]
甲状腺関連の上記以外の検査・治療 長崎甲状腺クリニック(大阪)
長崎甲状腺クリニック(大阪)とは
長崎甲状腺クリニック(大阪)は日本甲状腺学会認定 甲状腺専門医[橋本病,バセドウ病,甲状腺超音波(エコー)検査など]による甲状腺専門クリニック。大阪府大阪市東住吉区にあります。平野区,住吉区,阿倍野区,住之江区,松原市,堺市,羽曳野市,八尾市,天王寺区,東大阪市,生野区も近く。